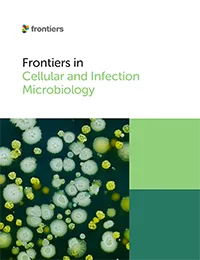
Frontiers in Cellular and Infection Microbiology

更多医学与健康科学期刊
Frontiers in Aging Neuroscience
The most cited journal in the field of geriatrics and gerontology, with research on central nervous system aging.
Acta Virologica
The Open Access journal of the Biomedical Research Centre of the Slovak Academy of Sciences.
Frontiers in Adolescent Medicine
Exploring all aspects of adolescent medicine to improve the health of our growing population.
Advances in Drug and Alcohol Research
The official journal of the International Drug and Alcohol Research Society and the International Narcotics Research Conference.
Frontiers in Anesthesiology
Explore research on perioperative medicine, anesthesia, and critical care aimed at improving patient outcomes.
Frontiers in Antibiotics
Discover research exploring solutions to antibiotic resistance, development and delivery to improve the health of the global population.
Frontiers in Audiology and Otology
Explore research on hearing, balance, and auditory disorders, advancing diagnostics, treatments, and rehabilitation technologies.
Frontiers in Aging
Explore research that advances our understanding of human aging and the fundamental link with age-related diseases.
Frontiers in Allergy
One of the most cited journals in its field, advancing our understanding of allergic diseases and how to manage them.
Frontiers in Biomaterials Science
Explore research on biomaterials science, integrating chemistry, biology, and engineering to advance biomedical innovations.
British Journal of Biomedical Science
Official journal of the Institute of Biomedical Science (IBMS).
Frontiers in Cardiovascular Medicine
Multidisciplinary journal publishing peer-reviewed research across basic, translational, and clinical cardiovascular medicine.
Frontiers in Cellular and Infection Microbiology
Explore peer-reviewed research on microbial pathogenesis, host-microbe interactions, and infection biology in this journal.
Frontiers in Cell Death
Discover cutting-edge research on apoptosis, necroptosis, and cell death pathways in this multidisciplinary journal.
Frontiers in Child and Adolescent Psychiatry
Explore open-access research exploring studies linking developmental science with psychiatry, paying particular attention to the first two decades of life.
Frontiers in Clinical Diabetes and Healthcare
Explore research on diabetes care and management, including topics such as prevention, patient outcomes and healthcare strategies improving clinical practice.
Frontiers in Digital Health
Explore open‑access research transforming healthcare with digital tools, covering topics like AI, big data, interoperability, ethics and personalized medicine.
Frontiers in Dental Medicine
Explore open-access research that investigates how dental, oral and craniofacial health and diseases are understood in the context of the whole body.
Frontiers in Dementia
Explore this open‑access journal accelerating clinical and translational dementia research—from risk factors to care, biomarkers, and molecular mechanisms.
Frontiers in Disaster and Emergency Medicine
Explore open‑access interdisciplinary research on disaster medicine, emergency health services, preparedness, and response to emerging global health crises.
Frontiers in Drug Delivery
Explore open‑access research on drug delivery systems, nanotechnology, targeting, and formulation to enhance therapeutic efficacy and patient outcomes.
Frontiers in Drug Discovery
Explore open-access research accelerating drug discovery from target identification and AI‑driven design to candidate development and translational therapies.
Frontiers in Drug Safety and Regulation
Explore open-access journal research in pharmacovigilance, pharmacoepidemiology, and policy to support evidence‑based decision‑making.
Dystonia
Dystonia aims to be the leading journal in the field by publishing open access premier research on all basic, clinical and translational aspects of the dystonias.
Frontiers in Endocrinology
The world's most cited endocrinology and metabolism journal, advancing understanding and treatment of hormonal disorders impacting health worldwide.
Frontiers in Environmental Health
Explore open‑access research into how the environment affects human health, covering air, housing, work, epidemiology and the policies that protect us.
Frontiers in Epidemiology
Explore open-access epidemiological research, covering methods, causes, outcomes, and inequalities in global epidemiology.
Frontiers in Epigenetics and Epigenomics
Explore open‑access research in epigenetics and epigenomics, uncovering cellular memory, gene regulation and disease mechanisms.
Experimental Biology and Medicine
A global, peer-reviewed journal dedicated to the publication of multidisciplinary and interdisciplinary research in the biomedical sciences.
Frontiers in Gastroenterology
Explore open-access research in digestive health, liver disease, infections, cancer and gastrointestinal care.
Frontiers in Hematology
Explore open-access research in hematology, covering blood disorders, therapies, immunology, and cellular processes.
International Journal of Public Health
An independent society journal owned by the non-profit Swiss School of Public Health (SSPH+). The journal is based in a fully independent Editorial Office and operates a rigorous double blind peer review process.
Frontiers in Immunology
Explore open-access research from the International Union of Immunological Societies (IUIS), leading the way across basic, translational and clinical immunology.
Frontiers in Imaging
Explore open‑access research in imaging with innovations in capture, processing and real‑world image applications.
Journal of Abdominal Wall Surgery
The aim of JAWS is to continue to provide committed support for surgeons and patients and to be an organ of scientific expression for all surgeons and researchers around the globe interested in abdominal wall surgery.
Journal of Cutaneous Immunology and Allergy
JCIA aims to be the leading journal in the field by publishing open access premier research covering the entire scope of cutaneous immunology and allergy, from molecular studies to clinical investigations and observations.
Journal of Pharmacy & Pharmaceutical Sciences
The first open access journal in the field established in 1998, is the official journal of the Canadian Society for Pharmaceutical Sciences (CSPS). JPPS is a broad-spectrum, peer-reviewed, international pharmaceutical journal.
Frontiers in Lupus
Explore open access research advancing the understanding, diagnosis and treatment of lupus.
Frontiers in Malaria
Explore open access research on all aspects of malaria, from transmission to treatment and prevention for effective control strategies.
Frontiers in Medical Engineering
Explore open access research in medical engineering, bridging engineering concepts and medical applications to advance healthcare.
Frontiers in Microbiomes
Explore open access research in microbiomes, uncovering how microbial communities shape health, environment and ecosystem dynamics.
Frontiers in Molecular Medicine
Explore open access research in molecular medicine, translating molecular insights into diagnostics and therapeutics for human disease.
Frontiers in Musculoskeletal Disorders
Explore open access research in musculoskeletal disorders, advancing understanding and treatment of bone, joint and tissue pathologies.
Frontiers in Medical Technology
Explore open access research in medical technology, driving innovation in diagnostics, treatment and global health solutions.
Frontiers in Medicine
Explore open access research in medicine, translating scientific discoveries into better diagnostics, treatments and patient outcomes.
Frontiers in Nephrology
Explore open access research in nephrology, advancing understanding of kidney health, disease mechanisms and therapeutic innovations.
Frontiers in Neuroimaging
Explore open access research in neuroimaging, advancing brain imaging methods to decode structure and function in health and disease.
Frontiers in Neurology
Explore open access research in neurology, advancing diagnosis, treatment and prevention of brain and nervous system disorders.
Frontiers in Nutrition
Explore open access research in nutrition, covering clinical nutrition, metabolism, food science, policy, sustainability and public health nutrition.
Frontiers in Network Physiology
Explore open access research in network physiology, mapping how physiological systems interact to maintain health or contribute to disease.
Frontiers in Nuclear Medicine
Explore open access research in nuclear medicine, advancing imaging, dosimetry, radiopharmacy, radiotherapy and data‑driven diagnostics.
Oncology Reviews
Advances our understanding of personalized medicine in oncology to develop targeted therapies for cancer treatment.
Frontiers in Oncology
Explore global oncology research advancing cancer diagnosis, treatment, and management across diverse populations and healthcare systems.
Frontiers in Oral Health
An exciting journal forging new pathways to improve oral and cardiometabolic health, therefore having a positive impact on overall health and wellness.
Frontiers in Ophthalmology
Advancing the understanding of eye health, covering vision disorders, diagnostics, and clinical treatments.
Frontiers in Parasitology
A go-to forum for the most important challenges in parasitology and parasitism - exploring and mitigating the impact of parasites on plants, animals, humans, and the wider society.
Pathology and Oncology Research
the Open Access journal of the Lajos Arányi Foundation. POR focuses on advances on the fields of experimental and clinical oncology, and pathology, bridging the gap between basic research and clinical medicine.
Public Health Reviews
An independent society journal owned by the non-profit Swiss School of Public Health (SSPH+). The journal is based in a fully independent Editorial Office and operates a rigorous double blind peer review process.
Frontiers in Pediatrics
This highly cited journal explores research that meets ongoing challenges in pediatric patient care and child health, from neonatal screening to adolescent development.
Frontiers in Pharmacology
The world's most cited pharmacology and pharmacy journal, advancing global pharmacological discoveries to prevent and treat human disease.
Frontiers in Psychiatry
The most cited psychiatry journal, using translational approaches to improve therapeutic options for mental illness, communicate progress to clinicians and researchers, and consequently to improve patient treatment outcomes.
Frontiers in Public Health
A highly cited multidisciplinary journal that promotes discussions on inter-sectoral public health challenges, from health promotion to climate change, transportation, environmental change, and species diversity.
Frontiers in Pain Research
An exciting journal covering mechanisms, treatments, socioeconomics, diagnostics, preventative measures and pain management in a range of medical specialties such as rheumatology and orthopedics.
Frontiers in Reproductive Health
An innovative interdisciplinary journal which explores human reproductive health - from STIs to reproductive epidemiology - to advance universal access to sexual and reproductive health care.
Frontiers in Radiology
An exciting journal, innovating every technical aspect of radiology and radiologist’s practice to improve quality, productivity and efficiency.
Frontiers in Rehabilitation Sciences
An innovative journal which investigates new ways to optimize the functioning and wellbeing of people who experience disability, focusing on rehabilitation as the health strategy of the 21st century.
Frontiers in Science
Transformational research, frameworks, and paradigms for accelerating solutions to global challenges - enriched by unique hubs of complementary content that engage and empower communities across all areas of science, policy, and society.
Frontiers in Sleep
A forum for innovation in basic, translational, epidemiologic and clinical sleep science, and its implications for physical and mental health.
Frontiers in Stroke
An innovative journal which provides a forum for research and advances in stroke medicine, from the genetics of stroke to population health and risk factors.
Frontiers in Surgery
A multidisciplinary journal which explores surgical practices - from fundamental principles to advances in microsurgery and minimally invasive techniques. It fosters innovation and improves the clinical management of patients.
Transplant International
TI aims to be the premier journal publishing basic science and clinical developments in organ replacement medicine, including all aspects of transplantation, organ reconditioning, cell therapy, regenerative medicine, bioengineering and artificial organs.
Frontiers in Transplantation
A multidisciplinary journal which communicates bench-to-bedside progress and breakthroughs in the ever-evolving transplant field, to improve clinical practice and save lives.
Frontiers in Tropical Diseases
Exploring the pathophysiology and control of tropical diseases with a focus on integrative prevention, control, and treatment methods, and the associated challenges in vulnerable populations.
Frontiers in Tuberculosis
A multidisciplinary journal focused on understanding the mechanisms behind the development, progression, treatment of tuberculosis and non-tuberculous mycobacterial infections.
Frontiers in Toxicology
A multidisciplinary journal which presents the latest research on the adverse effects of substances, particles and mixtures on living organisms.
Frontiers in Urology
An exciting journal which explores new frontiers in urology - from fundamental mechanisms of disease through clinical and surgical care, to prevention and population health research.